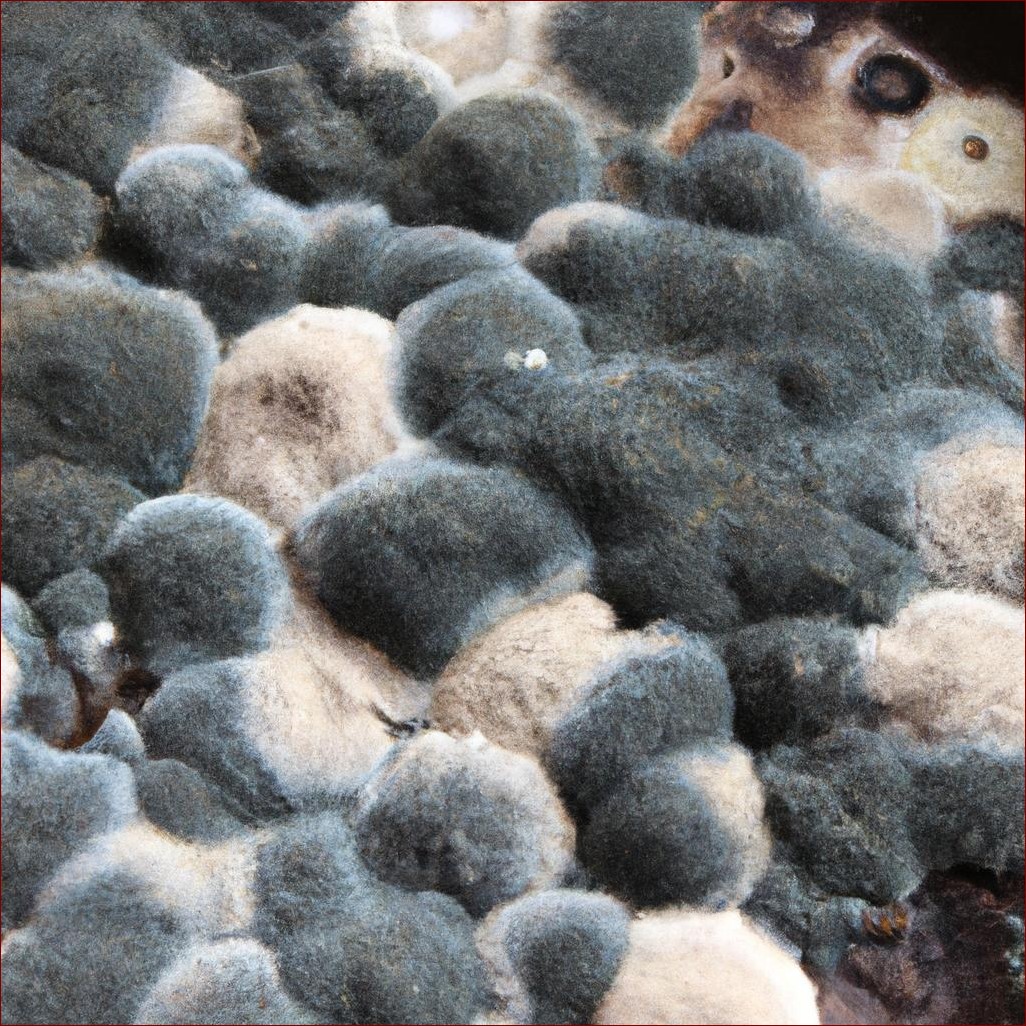
Grzyb na ścianie? Skuteczne metody usuwania pleśni i zapobiegania jej powrotowi

Grzyb na ścianie? Skuteczne metody usuwania pleśni i zapobiegania jej powrotowi
Jak pozbyć się grzyba na ścianie?
Grzyb na ścianie to problem, z którym zmaga się wielu właścicieli domów lub mieszkań. Taka pleśń nie tylko szpeci wygląd pomieszczeń, ale również może stanowić zagrożenie dla zdrowia. W tym artykule dowiesz się, jak skutecznie pozbyć się grzyba na ścianie i zapobiec jego ponownemu występowaniu.
Przyczyny powstawania grzybów na ścianach
Grzyby rozwijają się w wilgotnym i ciepłym środowisku, dlatego najczęstszymi przyczynami ich występowania są:
Nieszczelności
- Nieszczelne rury, przez które woda może wyciekać i powodować zawilgocenie ścian.
- Przecieki w dachu, które umożliwiają przedostawanie się wody deszczowej lub roztopionego śniegu.
- Pęknięcia w ścianach, przez które wilgoć może przenikać z gruntu lub innych pomieszczeń.
Nadmierna wilgotność
- Brak odpowiedniej wentylacji, co prowadzi do akumulacji wilgoci w pomieszczeniach.
- Skraplanie pary wodnej na chłodnych powierzchniach ścian, zwłaszcza w łazienkach i kuchniach.
- Nadmierne korzystanie z suszarek do ubrań lub innych urządzeń wytwarzających dużą ilość pary wodnej.
Identyfikacja rodzaju grzyba

Przed rozpoczęciem usuwania grzyba, ważne jest określenie z jakim rodzajem pleśni mamy do czynienia. Oto najczęściej występujące rodzaje grzybów na ścianach:
- Grzyb czarny (Stachybotrys) – Ciemne, czarne lub zielonkawe plamy o charakterystycznej "puszystej" strukturze. Wydzielają nieprzyjemny zapach i mogą wywoływać poważne reakcje alergiczne.
- Grzyb pleśniowy (Aspergillus) – Zielone, szare lub czarne plamy na ścianach. Często występuje w wilgotnych pomieszczeniach, takich jak łazienki i kuchnie.
- Grzyb różowiec (Aureobasidium) – Różowe lub czerwonawe plamy na ścianach. Często pojawia się w pobliżu okien lub innych miejsc narażonych na skraplanie wilgoci.
- Grzyb biały (Cladosporium) – Białe lub szare plamy na ścianach. Może wydzielać nieprzyjemny zapach i powodować reakcje alergiczne.
Kroki usuwania grzyba ze ścian
Przygotowanie powierzchni
Przed przystąpieniem do usuwania grzyba, należy odpowiednio przygotować powierzchnię. Zaleca się:
- Usunięcie luźnych fragmentów ściany, farby lub tynku w miejscach występowania grzybów.
- Odkurzenie i oczyszczenie powierzchni, aby usunąć wszelkie zanieczyszczenia i drobiny.
- Zabezpieczenie sąsiadujących powierzchni i mebli folią malarską lub arkuszami papieru.
- Zapewnienie odpowiedniej wentylacji w celu uniknięcia wdychania zarodników grzybów podczas pracy.
Zastosowanie środków grzybobójczych
Po przygotowaniu powierzchni należy użyć odpowiednich środków grzybobójczych w celu zniszczenia pleśni i zapobieżenia jej ponownemu występowaniu. Popularne środki to:

- Wybielacze na bazie chloru (np. woda utleniona)
- Preparaty na bazie czwartorzędowych związków amoniowych
- Rozpuszczalniki (np. alkohol izopropylowy)
- Preparaty na bazie kwasu borowego
Należy postępować zgodnie z instrukcjami producenta dotyczącymi stosowania i środków ostrożności.
Usunięcie pozostałości grzyba
Po skutecznym zastosowaniu środków grzybobójczych, należy usunąć pozostałości martwych grzybów. Można to zrobić za pomocą:
- Szczotki o sztywnym włosiu
- Szpachelki lub skrobaka
- Odkurzacza przemysłowego z filtrem HEPA
Wszystkie usunięte pozostałości należy natychmiast umieścić w szczelnie zamkniętych workach i wyrzucić do odpowiednich pojemników.
Naprawa uszkodzeń
Po całkowitym usunięciu grzybów, konieczne może być wykonanie napraw uszkodzonych powierzchni. Może to obejmować:

- Uzupełnienie ubytków w tynku lub betonie
- Nałożenie nowej warstwy gładzi lub szpachlówki
- Odmalowanie ściany po całkowitym wyschnięciu naprawionych fragmentów
Tabela podsumowująca kroki usuwania grzyba ze ścian:
| 1. Przygotowanie powierzchni | Usunięcie luźnych fragmentów, odkurzenie, zabezpieczenie otoczenia |
| 2. Zastosowanie środków grzybobójczych | Użycie odpowiednich preparatów zgodnie z instrukcjami |
| 3. Usunięcie pozostałości grzyba | Użycie szczotek, skrobaków, odkurzaczy |
| 4. Naprawa uszkodzeń | Uzupełnienie ubytków, szpachlowanie, malowanie |
Zapobieganie ponownemu występowaniu grzybów
Po skutecznym usunięciu grzyba należy podjąć kroki, aby zapobiec jego powrotnemu występowaniu.
Usunięcie źródła wilgoci
Kluczowe znaczenie ma wyeliminowanie źródła wilgoci, która umożliwia rozwój grzybów. Może to obejmować:
- Usunięcie nieszczelności w rurach, dachu lub ścianach.
- Odprowadzenie wody gruntowej lub opadowej od budynku.
- Ograniczenie stosowania urządzeń wytwarzających dużą ilość pary wodnej.
Poprawa wentylacji
Zapewnienie odpowiedniej wentylacji w pomieszczeniach jest niezbędne do utrzymania niskiego poziomu wilgotności. Można to osiągnąć poprzez:
- Montaż wentylatorów wyciągowych w łazienkach i kuchniach.
- Wykorzystanie naturalnej wentylacji, otwierając okna regularnie.
- Stosowanie osuszaczy powietrza w wilgotnych pomieszczeniach.
Zastosowanie środków impregnujących
Po usunięciu grzybów i naprawie uszkodzeń, warto zastosować środki impregnujące na ścianach. Tworzą one barierę ochronną, która utrudnia ponowny rozwój grzybów. Popularne środki impregnujące obejmują:
- Środki na bazie silikonu
- Preparaty z dodatkiem jonów srebra
- Impregnaty na bazie żywic akrylowych
Należy postępować zgodnie z instrukcjami producenta dotyczącymi stosowania i środków ostrożności.
Zakończenie
Usunięcie grzyba na ści



Opublikuj komentarz